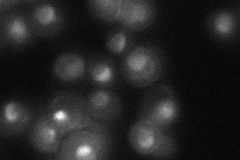
YDR529C

View description
Subunit 7 of the ubiquinol cytochrome-c reductase complex, which is a component of the mitochondrial inner membrane electron transport chain; oriented facing the mitochondrial matrix; N-terminus appears to play a role in complex assembly
Localization:
Intensity:
Fold change:
Significance:
-
C’ GFP library in SD

mitochondria216.69 -
N' NOP1pr-GFP in SD

nucleus,nucleolus96.5152 -
N' TEF2pr-mCherry in SD

nucleus,nucleolus60.9864 -
N' NATIVEpr-GFP in SD
nucleus,nucleolus38.2767 -
N' TEF2pr-VC and Cyto-VN in SD

nucleus,nucleolus55.8735 -
C’ GFP library in SD+DTT

mitochondria278.741.28No -
C’ GFP library in SD+H2O2

mitochondria153.890.71No -
C’ GFP library in Starvation Media

mitochondria313.711.44No -
C’ GFP library on the background of Pup2-DaMP

mitochondria -
C’ GFP library on the background of CCT mutant

mitochondria130.2390.60103Yes
